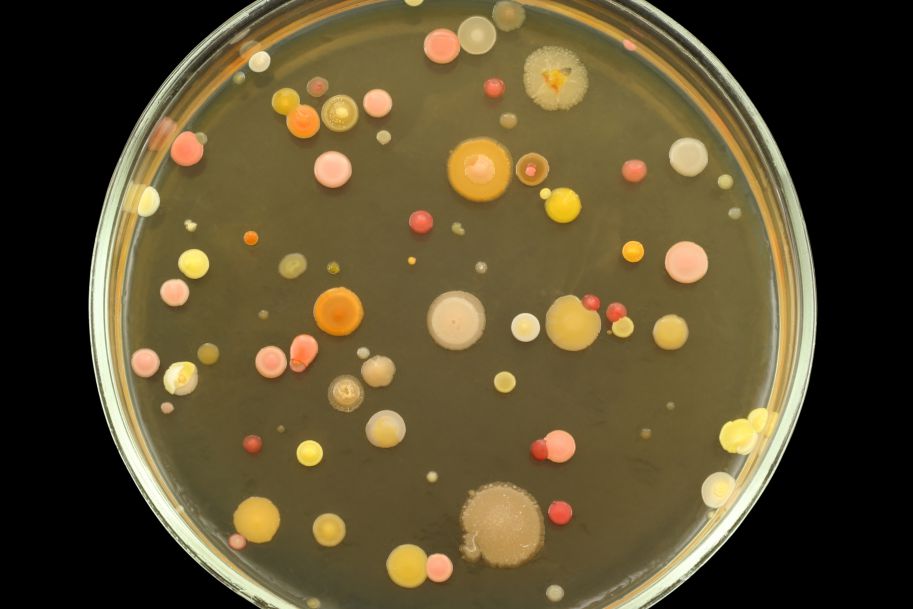

Podziel się z innymi:
2024-04-11
Mimo zaleceń WHO w Polsce wciąż brak elektronicznego rejestru przypadków sepsy
Źródło/Autor:
PAP
Rejestr umożliwiłby przede wszystkim wiarygodne monitorowanie liczby przypadków sepsy w Polsce, a to pozwoliłoby na szybką identyfikację wzrostów zachorowań oraz podejmowanie działań prewencyjnych i naprawczych.
Zobacz dalszy ciąg: Zaloguj się i przeczytaj pełną treść artykułu
Zarejestruj się
Nie masz jeszcze konta?
Zarejestruj się bezpłatnie i otrzymaj dostęp
do:
- niekomercyjnego biuletynu informacyjnego Goniec Medyczny. Trzy razy w tygodniu otrzymasz przegląd najbardziej interesujących informacji ze świata medycyny i farmacji,
- pełnych tekstów artykułów z wybranych polskich i zagranicznych czasopism naukowych,
- aktualnego kalendarza zjazdów, konferencji, szkoleń i innych wydarzeń medycznych.
Przeczytaj także:
Zdrowe osoby mogą uniknąć zakażenia grypą nawet po kilku dniach przebywania z chorymi w zamkniętej przestrzeni. Eksperyment naukowców z Uniwersytetu Maryland pokazał, że kluczowa dla zatrzymania transmisji jest dobra wentylacja.
14.01.2026
W poniedziałek przed Sądem Rejonowym w Szczecinku zakończył się proces pielęgniarki Ewy B. oskarżonej o zaszczepienie 40 dzieci nieustaloną substancją. Prokurator i oskarżyciel posiłkowy żądają dla niej kary trzech lat więzienia. Obrońca liczy na uniewinnienie. Sąd wyda wyrok 26 stycznia.
14.01.2026
Kolejne szpitale zamykają oddziały położniczo-ginekologiczne. Powodem jest demografia, czyli zmniejszająca się liczba urodzeń. Ministerstwo Zdrowia zaproponowało rozwiązanie: jeśli do szpitala bez porodówki trafi rodząca kobieta, gotowa do udzielenia pomocy ma być dyżurująca tam położna.






